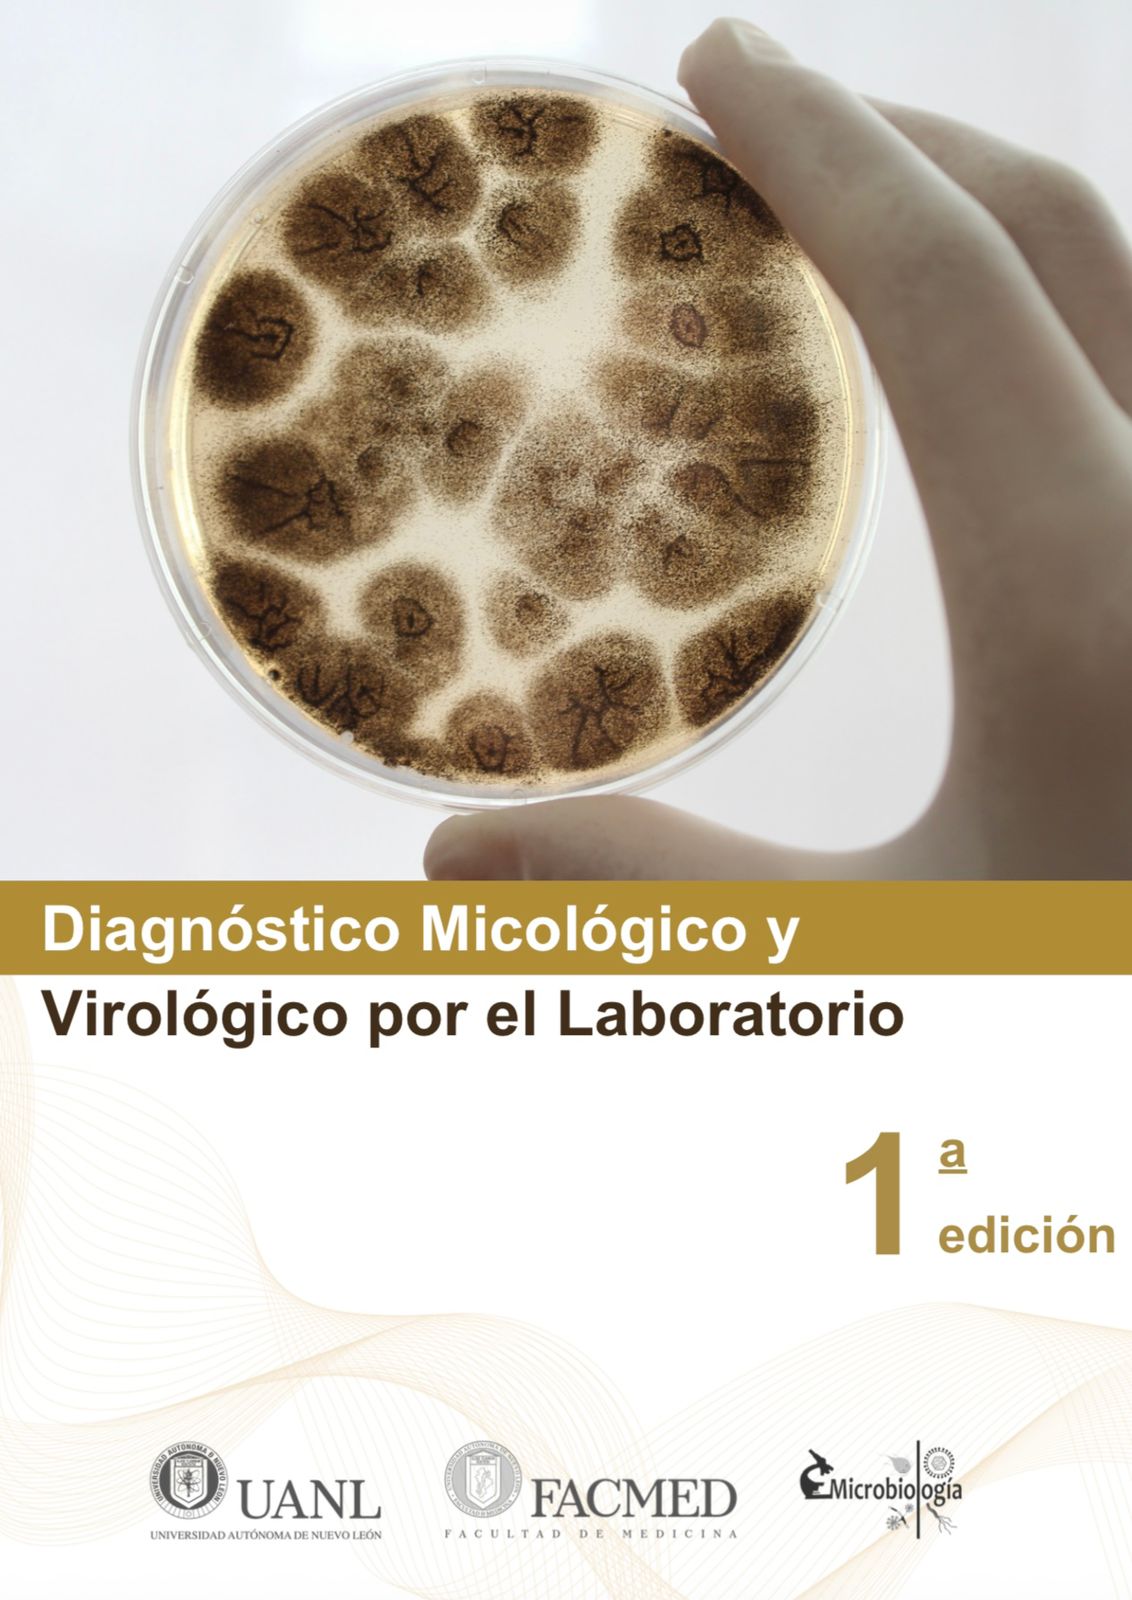

¡Tu carrito está actualmente vacío!
Diagnóstico Micológico y Virológico por el Laboratorio
Versión digital en PDF del manual «Diagnóstico micológico y virológico por el laboratorio». Una guía práctica e ilustrada para el estudio y diagnóstico de hongos y virus de importancia médica. Ideal para estudiantes y profesionales de Química Clínica y áreas afines. ¡Descarga inmediata!
Descripción
Diagnóstico Micológico y Virológico por el Laboratorio (versión digital – PDF)
Tu guía digital para dominar las prácticas de laboratorio en micología y virología médica.
Esta edición digital ha sido elaborada por el Departamento de Microbiología de la Facultad de Medicina de la UANL como un recurso formativo esencial para estudiantes y personal de laboratorio clínico. Su enfoque práctico e ilustrado permite comprender las principales técnicas empleadas en el diagnóstico de infecciones fúngicas y virales, integrando fundamentos teóricos, esquemas, imágenes y procedimientos paso a paso que facilitan la aplicación directa en entornos académicos y hospitalarios.
📘 Contenido del libro:
- Introducción a la recolección, transporte y procesamiento de muestras clínicas para estudios micológicos y virológicos.
- Cultivo e identificación de hongos filamentosos, levaduras y dermatofitos de interés médico.
- Tinciones y pruebas bioquímicas para la caracterización de micosis superficiales, subcutáneas y sistémicas.
- Métodos inmunológicos y moleculares básicos para el diagnóstico viral (inmunofluorescencia, ELISA, PCR).
- Secciones prácticas con protocolos estandarizados, esquemas de trabajo, y fichas para registro de resultados.
- Apartado de bioseguridad y buenas prácticas en el manejo de agentes infecciosos.
💻 Ventajas de la versión digital:
- Acceso inmediato tras la compra.
- Perfecto para estudiar desde tu computadora, tablet o smartphone.
- Puedes imprimir secciones específicas para consulta en laboratorio.
- Formato compatible con cualquier lector de PDF.
🎯 Dirigido a:
Estudiantes de Química Clínica, Medicina, Biología, Técnicos laboratoristas, docentes y profesionales del área de la salud interesados en el diagnóstico micológico y virológico desde una perspectiva práctica y aplicada.
📄 Formato:
Archivo digital en PDF | 124 páginas | Descarga inmediata